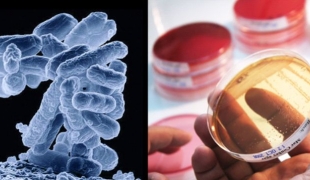

Antibiorésistance
Les équipes de Médecins Sans Frontières mettent en œuvre un large éventail de soins : consultations, hospitalisations, interventions chirurgicales, soins psychologiques, soins médico-nutritionnels etc. dans des contextes d’urgence ou de difficultés d’accès aux soins.
Derniers communiqués de presse
Rapport de l’OMS sur la résistance aux antibiotiques : MSF confirme l’état d…
Communiqué de presse